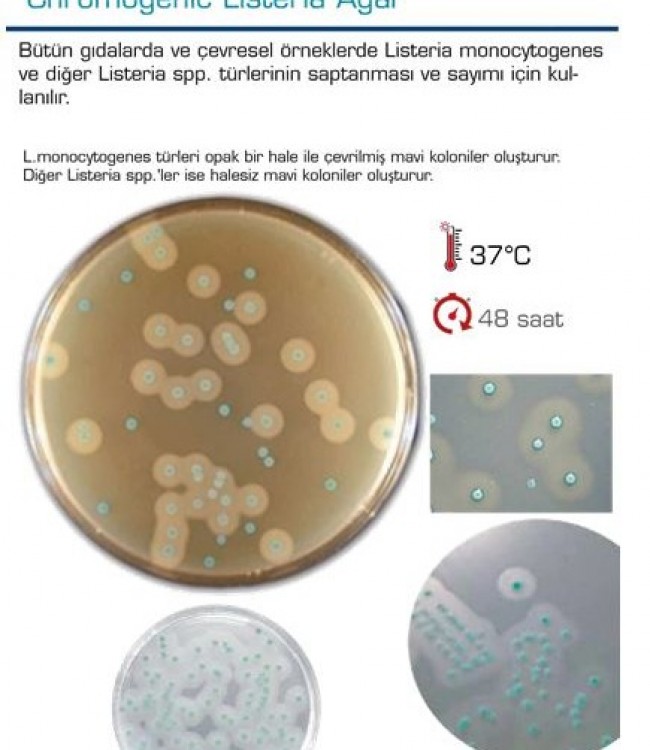

Chromogenic Listeria Agar
Chromogenic Listeria Agar
Bütün gıdalarda ve çevresel örneklerde Listeria monoçytogenes ve diğer Listeria spp. türlerinin saptanması ve sayımı için kul-
lanılır.
L.monoçytogenes türleri opak bir hale ile çevrilmiş mavi koloniler oluşturur.
Diğer Listeria spp.'ler ise halesiz mavi koloniler oluşturur.